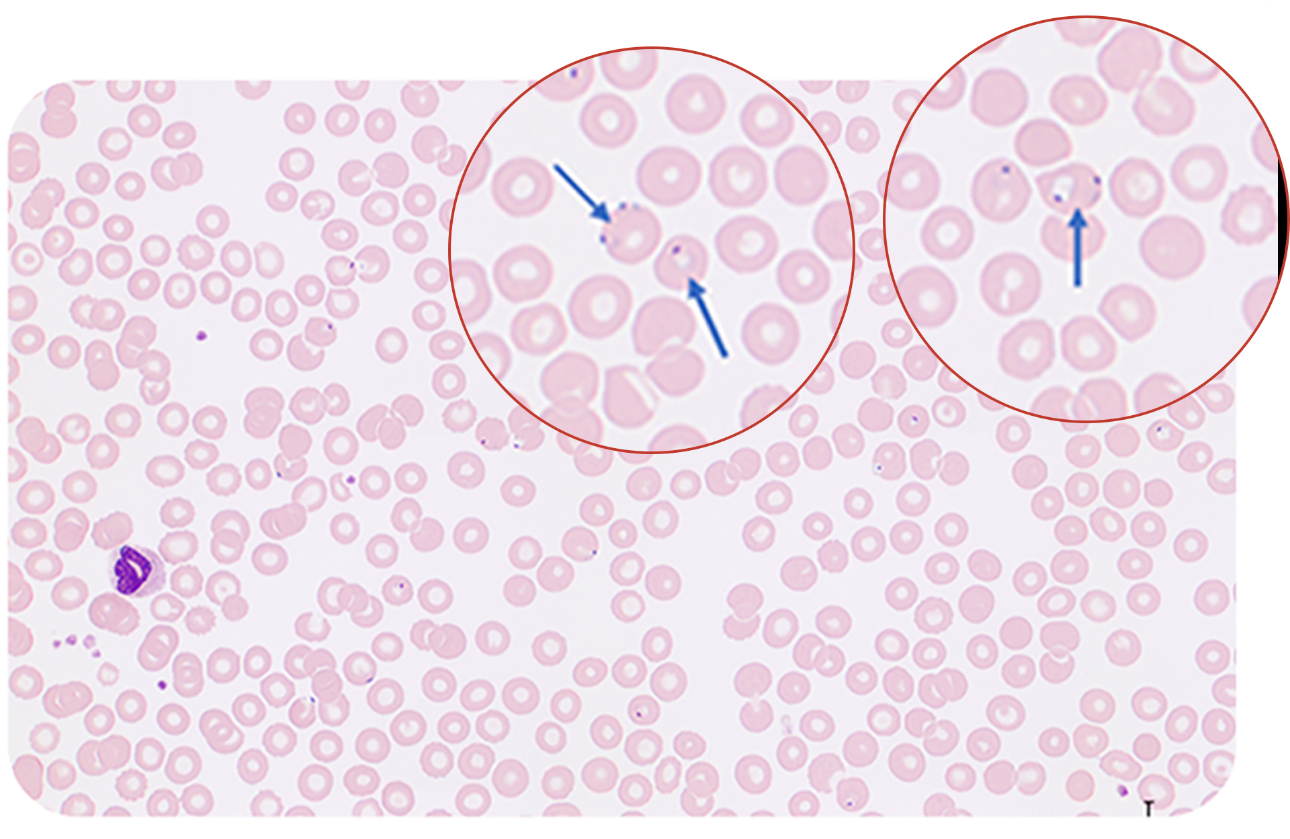
maurer-pigment-fig7-pc

Quick Facts about Malaria
According to the World Health Organization (WHO), there were an estimated 241 million cases of malaria worldwide in 2020, and the estimated number of malaria deaths stood at 627,000 in that year. The African Region was home to 95% of malaria cases and 96% of malaria deaths. Children under 5 accounted for an estimated 80% of all malaria deaths in the Region.1

Diagnostic Gold Standard
In the guidelines of the Centers for Disease Control and Prevention (CDC), malaria can be diagnosed using three common methods: microscopy, rapid diagnostic test (RDTs), and serology. Microscopic examination remains the ŌĆ£gold standardŌĆØ for laboratory confirmation of malaria. Species determination is made based on the morphological characteristics of the four species of human malaria parasites and the infected red blood cells. In addition, all positive RDTs should be followed by microscopy.

These tests should be performed immediately without delay when ordered by a health-care provider. It is vital that health-care providers receive results from these tests within hours in order to appropriately treat their patients infected with malaria.2
?
However, many factors can influence a laboratory's choice of microscopy as a diagnostic tool for malaria, including the skills of laboratory staff, patient sample testing load, and epidemiology of malaria and possible use of microscopy for other diseases.3
A Clinical Case Study
In Europe, around 8,000 cases of imported malaria are reported every year, the majority due to Plasmodium falciparum (P. falciparum).4? The rise in malaria infections has become a concern of Spain.5 6?It is important to get diagnosis clues through the microscopic results from front-line checks, so doctors can act quickly and provide effective treatment for the infected immigrants and summer travelers.
?
Dr. Anna Merino from the Core Laboratory, Hospital Clinic, in Barcelona, Spain, shared a recent case in her laboratory.
?
A 48-year-old man was admitted to the hospital with a high fever. A blood cell check was done on the Mindray BC-6800Plus hematology analyzer. The low platelet count result (66 x 109/L) and flags on immature granulocytes, atypical lymphocytes, and an abnormal PLT histogram triggered the re-exam rules.

Therefore, a blood smear test was performed on the Mindray SC-120 Auto Slide Maker and Stainer. Then, the smear was loaded onto the Mindray MC-80 Automatic Digital Morphology System. A couple of minutes later, the scanning was completed.

Several important morphological findings were revealed in validating the cells. The presence of inclusions within red blood cells (RBCs) was the first and most important finding, which corresponded to malaria-derived parasites. Another important finding was the malaria-derived pigments inside of neutrophils (Maurer pigments).

Atypical lymphocytes, as flagged by the hematology analyzer, were found in the smear. Some lymphocytes also contained malaria-derived pigments.

With a careful look at the RBC scanning screen, several infected RBCs could be found (indicated by the arrows).
From Dr. Anna MerinoŌĆÖs experience, ŌĆ£The image clearly shows a blood sample corresponding to a patient infected by malaria (P. falciparum species) as we can observe two or more parasites inside RBCs and two dots of chromatin.ŌĆØ A quick report was made and handed to the clinicians. The anaylysis of a thick drop in the microbiology laboratory confirmed the diagnosis. During the following medical consulation, the patient admitted that he once travelled to the Ivory coast in western Africa. The patient received treatment with Artesunate (Eurartesim(R) 320/40 mg) immediately and recovered quickly as expected.
?
As a new digital morphology system, the Mindray MC-80 provides faster scanning and clearer visualization of the conditions to facilitate the traditional microscopic examination, enabling accurate diagnosis and effective treatment through modern clinical testing procedures.

Reference:
[1] https://www.who.int/news-room/fact-sheets/detail/malaria
[2] https://www.cdc.gov/malaria/diagnosis_treatment/diagnostic_tools.html
[3] Ngasala, B., Bushukatale, S. Evaluation of malaria microscopy diagnostic performance at private health facilities in Tanzania. Malar J 18, 375 (2019).
[4] European Centre for Disease Prevention and Control. Malaria. In: ECDC. Annual epidemiological report for 2018. Stockholm: ECDC; 2020.
[5] Pousibet-Puerto, J., Lozano-Serrano, A.B., Soriano-P├®rez, M.J. et al. Migration-associated malaria from Africa in southern Spain. Parasites Vectors 14, 240 (2021).
[6] Dom├Łnguez Garc├Ła, M., Feja Solana, C., Vergara Ugarriza, A. et al. Imported malaria cases: the connection with the European ex-colonies. Malar J 18, 397 (2019).



